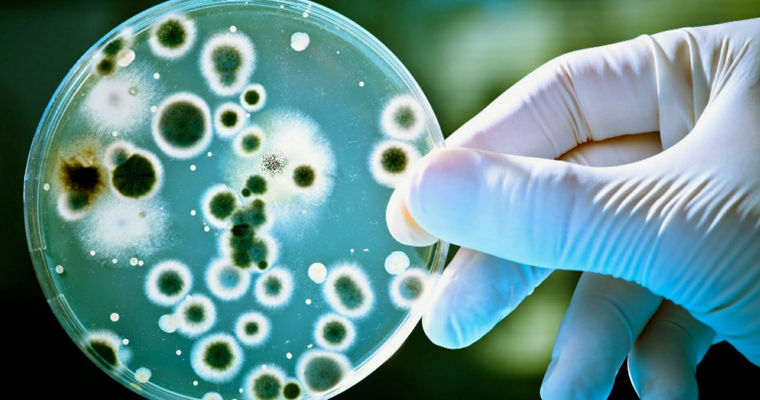

Ученые призвали прекратить исследования по созданию «зеркальных» бактерий
The Guardian: биологи заявили об угрозе зеркальных микробов для жизни на Земле.
Ведущие ученые мира призвали отказаться от проведения исследований по созданию «зеркальных» микробов в связи с опасениями, что синтетические организмы могут стать угрозой для жизни на Земле. Об этом пишет газета The Guardian, передает gazeta.ru
Из материала следует, что 12 декабря в журнале Science появились доклад о рисках инновационной технологии и статья с предупреждением об ее опасности для живых существ. В частности, авторы первой публикации предложили организовать глобальную дискуссию по поводу целесообразности создания «зеркальных» микробов.
«Угроза, о которой мы говорим, беспрецедентна. «Зеркальные» бактерии, вероятно, обойдут многие реакции иммунной системы человека, животных и растений и в каждом случае будут вызывать <...> инфекции, которые будут распространяться без всяких ограничений», — рассказал один из авторов доклада, эволюционный биолог из Питтсбургского университета Вон Купер.
Журналисты уточнили, что вместе с ним против поспешного создания «зеркальных» микробов выступили американский ученый Крейг Вентер и два лауреата Нобелевской премии. Ими оказались профессор из Чикагского университета Джек Шостак и профессор из Кембриджского университета Грег Винтер.
Как отмечается в подготовленном ими докладе, перед созданием «зеркальных» бактерий надо собрать убедительные доказательства, что эти микробы не будут представлять «чрезвычайной опасности» для жизни на Земле. До тех пор исследования в этой области проводить нельзя, уверены специалисты.
«Мы рекомендуем не допускать исследований, целью которых является создание «зеркальных» бактерий, и отказаться от их финансирования», — подчеркивается в публикации.
В статье The Guardian отмечается, что многие из необходимых для жизни молекул могут существовать в двух разных формах. При этом каждая из них является зеркальным отражением другой.
Так, ДНК всех живых существ состоит из «правосторонних» нуклеотидов. Белки и строительные блоки клеток, в свою очередь, включают в себя «левосторонние» аминокислоты. К текущему моменту ученым уже удалось создать функциональные «зеркальные» молекулы, и теперь они работают над изготовлением «зеркальных» микробов.